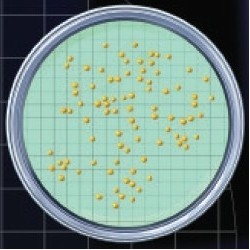

NPS
Nutrient pad sets (NPS) = milieux de culture stériles déshydratés sur un support en carton.
Ils sont prêts à l'emploi immédiatement après addition de 3,5 ml d'eau stérile.
Les NPS permettent une croissance plus rapide en comparaison aux mileux gélosés.
Conditionnement: 50 boites de Pétri et 50 membranes stériles en emballage individuel.
Durée de conservation: 2 ans à température ambiante.